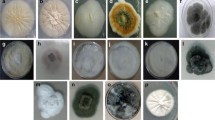

Abstract
Induced biosynthesis of bioactive secondary metabolites constitutes one of the mechanisms of plant basal innate immunity to fungal infection. Metabolic changes were studied in rhizomes of Zingiber zerumbet, a wild congener of ginger, after infection with soft rot-causative necrotrophic phytopathogen, Pythium myriotylum, by gas chromatography-mass spectrometry (GC-MS) analysis. Infection triggered a considerable alteration in the relative content of zerumbone and α-caryophyllene (humulene) with enhancement in zerumbone content (81.59 %) and that of α-caryophyllene (11.91 %) compared to 9.97 and 1.11 %, respectively, in uninfected rhizomes. While zerumbone is the principal secondary metabolite in Z. zerumbet, α-caryophyllene is its immediate precursor. Principal component analysis (PCA) identified the correlations between metabolite changes in Z. zerumbet rhizomes and P. myriotylum infection. Radial diffusion assay with zerumbone indicated a concentration-dependent P. myriotylum growth inhibition with 93.75 % inhibition observed at 700 μg and 50 % maximal effective concentration (EC50) value of 206 μg. Scanning electron microscopy (SEM) analysis revealed that the mechanistic basis of zerumbone’s antagonistic action on P. myriotylum growth involved the induction of aberrant morphology including severe hyphal deformities and membrane disruption. Results are discussed highlighting the critical role played by sesquiterpenoid zerumbone in affording resistance in Z. zerumbet and could expedite the development of appropriate strategies for biocontrol of Pythium spp., thus reducing the usage of broad-spectrum fungicides.




Similar content being viewed by others
References
Selvan, M. T., Thomas, K. G., & Manojkumar, K. (2002). In H. P. Singh, K. Sivaraman, & M. T. Selvan (Eds.), Indian spices—production and utilization: ginger (Zingiber officinale Rosc.) (pp. 110–131). India: Coconut Development Board.
Endo, K., Kanno, E., & Oshima, Y. (1990). Structures of antifungal diarylheptenones, gingerenones A, B, C and isogingerenone B, isolated from the rhizome of Zingiber officinale. Phytochemistry, 29(3), 797–799.
Ali, S. E., El-Shaffey, A. A., Selim, M. E., El-massry, K. F., & Sabry, B. A. (2011). Chemical profile, antioxidant, antifungal and antiaflatoxigenic activity of Parsley and Ginger volatile and non-volatile extracts. Journal of Biologically Active Products from Nature, 1(1), 81–96.
Gugnani, H. C., & Ezenwanze, E. C. (1985). Antibacterial activity of extracts of ginger (Zingiber officinale) and African oil bean seed (Pentaclethora macrophylla). Journal of Communicable Diseases, 17, 233–236.
Gull, I., Saeed, M., Shaukat, H., Aslam, S. M., Samra, Z. Q., & Athar, A. M. (2012). Inhibitory effect of Allium sativum and Zingiber officinale extracts on clinically important drug resistant pathogenic bacteria. Annals of Clinical Microbiology and Antimicrobials, 11, 8.
Wang, H., & Ng, T. B. (2005). An antifungal protein from ginger rhizomes. Biochemical and Biophysical Research Communications, 336(1), 100–104.
Parthasarathy, V. A., Srinivasan, V., Nair, R. R., Zachariah, T. J., Kumar, A., & Prasath, D. (2012). In J. Janick (Ed.), Horticulture reviews, vol. 39: ginger: botany and horticulture (pp. 273–388). New Jersey: Wiley-Blackwell.
Al-Amoudi, W. M. (2012). Haematological and biochemical effects of metalaxyl fungicide on albino mice. American Journal of Biochemistry, 2(5), 62–66.
Monkiedje, A., & Spiteller, M. (2002). Effects of the phenylamide fungicides, mefenoxam and metalaxyl, on the microbiological properties of a sandy loam and a sandy clay soil. Biology and Fertility of Soils, 35, 393–398.
Dowley, L. J., & O’Sullivan, E. (1981). Metalaxyl-resistant strains of Phytophthora infestans (Mont.) de Bary in Ireland. Potato Research, 24, 417–421.
Chen, I. N., Chang, C. C., Ng, C. C., Wang, C. Y., Shyu, Y. T., & Chang, T. L. (2008). Antioxidant and antimicrobial activity of Zingiberaceae plants in Taiwan. Plant Foods for Human Nutrition, 63, 15–20.
Singh, C. B., Nongalleima, K., Brojendrosingh, S., Ningombam, S., Lokendrajit, N., & Singh, L. W. (2012). Biological and chemical properties of Zingiber zerumbet Smith: a review. Phytochemistry Reviews, 11, 113–125.
Kavitha, P. G., & Thomas, G. (2007). Evaluation of Zingiberaceae for resistance to ginger soft rot caused by Pythium aphanidermatum (Edson) Fitzp. Plant Genetic Resources Newsletter, 152, 1–4.
Garodia, P., Ichikawa, H., Malani, N., Sethi, G., & Aggarwal, B. B. (2007). From ancient medicine to modern medicine: ayurvedic concepts of health and their role in inflammation and cancer. Journal of the Society for Integrative Oncology, 5(1), 25–37.
Yob, N. J., Mohd. Jofrry, S., Meor. Mohd. Affandi, M. M. R., Teh, L. K., Salleh, M. Z., & Zakaria, Z. A. (2011). Zingiber zerumbet (L.) Smith: A review of its ethnomedicinal, chemical and pharmacological uses. Evidence-Based Complementary and Alternative Medicine, 543216, 1–12.
Srivastava, A. K., Srivastava, S. K., & Shah, N. C. (2000). Essential oil composition of Zingiber zerumbet (L.) Sm. from India. Journal of Essential Oil Research, 12, 595–597.
Rout, K. K., Mishra, S. K., & Sherma, J. (2009). Development and validation of an HPTLC method for analysis of Zerumbone, the anticancer marker from Zingiber zerumbet. Acta Chromatographica, 21(3), 443–452.
Hossain, M. A., Ismail, Z., Rahman, A., & Kang, S. C. (2008). Chemical composition and anti-fungal properties of the essential oils and crude extracts of Orthosiphon stamineus Benth. Industrial Crops and Products, 27, 328–334.
Aswati, N. R., & Thomas, G. (2007a). Evaluation of resistance gene (R-gene) specific primer sets and characterization of resistance gene candidates in ginger (Zingiber officinale Rosc.). Current Science, 93, 61–66.
Aswati, N. R., & Thomas, G. (2007b). Isolation, characterization, diversity analysis and expression studies of resistance gene candidates (RGCs) from Zingiber spp. Theoretical and Applied Genetics, 116, 123–134.
Kavitha, P. G., & Thomas, G. (2008). Defence transcriptome profiling of Zingiber zerumbet (L.) Smith by mRNA differential display. Journal of Biosciences, 33, 81–90.
Aswati, N. R., Kiran, A. G., Sivakumar, K. C., & Thomas, G. (2010). Molecular characterization of an oomycete-responsive PR-5 protein gene from Zingiber zerumbet. Plant Molecular Biology Reporter, 28, 128–135.
Finney, D. J. (1952). Probit analysis. A statistical treatment of the sigmoid response curve. ed., Cambridge University Press, Cambridge.
Islam, M. T., Ito, T., & Tahara, S. (2001). Morphological studies on zoospores of Aphanomyces cochlioides and changes during interaction with host materials. Journal of General Plant Pathology, 67, 255–261.
Dixon, R. A. (2001). Natural products and plant disease resistance. Nature, 411, 843–847.
Sabulal, B., Sabulal, B., Dan, M., John, A. J., Kurup, R., Pradeep, N. S., et al. (2006). Caryophyllene-rich rhizome oil of Zingiber nimmonii from South India: Chemical characterization and antimicrobial activity. Phytochemistry, 67(22), 2469–2473.
Cheikh-Ali, Z., Adiko, M., Bouttier, S., Bories, C., Okpekon, T., Poupon, E., & Champy, P. (2011). Composition, and antimicrobial and remarkable antiprotozoal activities of the essential oil of rhizomes of Aframomum sceptrum K. Schum. (Zingiberaceae). Chemistry and Biodiversity, 8(4), 658–667.
Karabay-Yavasoglu, N. U., Sukatar, A., Ozdemir, G., & Horzum, Z. (2007). Antimicrobial activity of volatile components and various extracts of the red alga Jania rubens. Phytotherapy Research, 21(2), 153–156.
Vukovic, N., Sukdolak, S., Solujic, S., & Niciforovic, N. (2009). Antimicrobial activity of the essential oil obtained from roots and chemical composition of the volatile constituents from the roots, stems and leaves of Ballota nigra from Serbia. Journal of Medicinal Food, 12(2), 435–441.
Kala, S. M. J., Balasubramanian, T., Soris, P. T., & Mohan, V. R. (2011). GC-MS determination of bioactive components of Eugenia singampattiana Bedd. International Journal of ChemTech Research, 3(3), 1534–1537.
Lee, Y. (2013). Activation of apoptotic protein in U937 cells by a component of turmeric oil. BMB Reports, 42(2), 96–100.
Yue, G. G., Cheng, S.-W., Yu, H., Xu, Z.-S., Lee, J. K., Hon, P.-M., et al. (2012). The role of turmerones on curcumin transportation and P-glycoprotein activities in intestinal Caco-2 cells. Journal of Medicinal Food, 15(3), 242–252.
Ley, J. P., Engelhart, K., Bernhardt, J., & Bertram, H.-J. (2002). 3,4-Dihydroxymandelic acid, a noradrenalin metabolite with powerful antioxidative potential. Journal of Agricultural and Food Chemistry, 50(21), 5897–5902.
Ezhilan, B. P., & Neelamegam, R. (2012). GC-MS analysis of phytocomponents in the ethanol extract of Polygonum chinense L. Pharmacognosy Research, 4(1), 11–14.
Li, M., Zhou, L., Yang, D., Li, T., & Li, W. (2012). Biochemical composition and antioxidant capacity of extracts from Podophyllum hexandrum rhizome. BMC Complementary and Alternative Medicine, 12, 263–270.
Swiedrych, A., Lorenc-Kukuła, K., Skirycz, A., & Szopa, J. (2004). The catecholamine biosynthesis route in potato is affected by stress. Plant Physiology and Biochemistry, 42, 593–600.
Fyfe, L., Armstrong, F., & Stewart, J. (1998). Inhibition of Listeria monocytogenes and Salmonella enteriditis by combinations of plant oils and derivatives of benzoic acid: The development of synergistic antimicrobial combinations. International Journal of Antimicrobial Agents, 9, 195–199.
Ivanova, A., Delcheva, I., Tsvetkova, I., Kujumgiev, A., & Kostova, I. (2002). GC-MS analysis and anti-microbial activity of acidic fractions obtained from Paeonia peregrina and Paeonia tenuifolia roots. Zeitschrift für Naturforschung C, 57c, 624–628.
Papadopoulou, C., Soulti, K., & Roussis, I. G. (2005). Potential antimicrobial activity of red and white wine phenolic extracts against strains of Staphylococcus aureus, Escherichia coli and Candida albicans. Food Technology and Biotechnology, 43(1), 41–46.
Yalpani, N., Leon, J., Lawton, M. A., & Raskin, I. (1993). Pathway of Salicylic acid biosynthesis in healthy and virus- inoculated tobacco. Plant Physiology, 103, 315–321.
Qualley, A. V., Widhalm, J. R., Adebesin, F., Kish, C. M., & Dudareva, N. (2012). Completion of the core β-oxidative pathway of benzoic acid biosynthesis in plants. PNAS, 109(40), 16383–16388.
Holland, J. N., Chamberlain, S. A., & Horn, K. C. (2009). Optimal defence theory predicts investment in extrafloral nectar resources in an ant–plant mutualism. Journal of Ecology, 97, 89–96.
Banchio, E., Zygadlo, J., & Valladares, G. R. (2005). Quantitative variations in the essential oil of Minthostachys mollis (Kunth.) Griseb. in response to insects with different feeding habits. Journal of Agricultural and Food Chemistry, 53, 6903–6906.
Frischknecht, P. M., Battig, M., & Baumann, T. W. (1987). Effect of drought and wounding stress on indole alkaloid formation in Catharanthus roseus. Phytochemistry, 26, 707–710.
Baldwin, I. T., Zhang, Z.-P., Diab, N., Ohnmeiss, T. E., McCloud, E. S., Lynds, G. Y., & Schmelz, E. A. (1997). Quantification, correlations and manipulations of wound-induced changes in jasmonic acid and nicotine in Nicotiana sylvestris. Planta, 201, 397–404.
Bodnaryk, R. P. (1992). Effects of wounding on glucosinolates in the cotyledons of oilseed rape and mustard. Phytochemistry, 31, 2671–2677.
Osbourn, A. E. (1996). Preformed antimicrobial compounds and plant defence against fungal attack. Plant Cell, 8, 1821–1831.
Edreva, A., Velikova, V., Tsonev, T., Dagnon, S., Gürel, A., Aktaş, L., & Gesheva, E. (2008). Stress-protective role of secondary metabolites: diversity of functions and mechanisms. General and Applied Plant Physiology, 34(1–2), 67–78.
Paiva, N. (2000). An introduction to the biosynthesis of chemicals used in plant-microbe communication. Journal of Plant Growth Regulation, 19, 131–143.
Iriti, M., & Faoro, F. (2009). Chemical diversity and defence metabolism: How plants cope with pathogens and ozone pollution. International Journal of Molecular Sciences, 10(8), 3371–3399.
Balmer, D., Flors, V., Glauser, G., & Mauch-Mani, B. (2013). Metabolomics of cereals under biotic stress: current knowledge and techniques. Frontiers in Plant Science, 4(82), 1–12.
Huang, G. C., Chien, T. Y., Chen, L. G., & Wang, C. C. (2005). Antitumor effects of zerumbone from Zingiber zerumbet in P-388D1 cells in vitro and in vivo. Planta Medica, 71(3), 219–224.
Sakinah, S. A. S., Handayani, S. T., & Hawariah, L. P. A. (2007). Zerumbone induced apoptosis in liver cancer cells via modulation of Bax/Bcl-2 ratio. Cancer Cell International, 7, 4.
Yodkeeree, S., Sung, B., Limtrakul, P., & Aggarwal, B. B. (2009). Zerumbone enhances TRAIL-induced apoptosis through the induction of death receptors in human colon cancer cells: Evidence for an essential role of reactive oxygen species. Cancer Research, 69(16), 6581–6589.
Kishore, N., & Dwivedi, R. S. (1992). Zerumbone: a potential fungitoxic agent isolated from Zingiber cassumunar Roxb. Mycopathologia, 120, 155–159.
De Billerbeck, V. G., Roques, C. G., Bessiere, J. M., Fonvieille, J. L., & Dargent, R. (2001). Effects of Cymbopogon nardus (L.) W. Watson essential oil on the growth and morphogenesis of Aspergillus niger. Canadian Journal of Microbiology, 47, 9–17.
Liu, X., Wang, L. P., Li, Y. C., Li, H. Y., Yu, T., & Zheng, X. D. (2009). Antifungal activity of thyme oil against Geotrichum citri-aurantii in vitro and in vivo. Journal of Applied Microbiology, 107, 1450–1456.
Castillo, F., Hernández, D., Gallegos, G., Mendez, M., Rodríguez, R., Reyes, A., & Aguilar, C. N. (2010). In vitro antifungal activity of plant extracts obtained with alternative organic solvents against Rhizoctonia solani Kühn. Industrial Crops and Products, 32, 324–328.
Abdel-Monaim, M. F., Abo-Elyousr, K. A. M., & Morsy, K. M. (2011). Effectiveness of plant extracts on suppression of damping-off and wilt diseases of lupine (Lupinus termis Forsik). Crop Protection, 30, 185–191.
Plodpai, P., Chuenchitt, S., Petcharat, V., Chakthong, S., & Voravuthikunchai, S. P. (2013). Anti-Rhizoctonia solani activity by Desmos chinensis extracts and its mechanism of action. Crop Protection, 43, 65–71.
Acknowledgments
The authors are grateful to the Department of Science and Technology (DST), Government of India, for the research funding (No. SR/FT/LS-052/2009) received. KD and GC acknowledge the research fellowship received from Ministry of Human Resource and Development (MHRD), Government of India. PP thanks the Director of JNTBGRI, Kerala, India, for the research facilities extended. We gratefully acknowledge RGCB and IISR for providing us with P. myriotylum strain (RGCBN14) and rhizome samples, respectively.
Author information
Authors and Affiliations
Corresponding author
Rights and permissions
About this article
Cite this article
Keerthi, D., Geethu, C., Nair, R.A. et al. Metabolic Profiling of Zingiber zerumbet Following Pythium myriotylum Infection: Investigations on the Defensive Role of the Principal Secondary Metabolite, Zerumbone. Appl Biochem Biotechnol 172, 2593–2603 (2014). https://doi.org/10.1007/s12010-013-0707-z
Received:
Accepted:
Published:
Issue Date:
DOI: https://doi.org/10.1007/s12010-013-0707-z